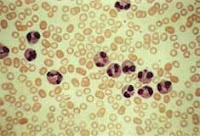

El eosinófilo es un granulocito pequeño derivado de la médula ósea, estimulado por la IL 5, IL3, y el Factor estimulante de colonias Granulocito-Macrofágico.Tiene una vida media en circulación de 3 a 4 días, antes de migrar a los tejidos donde vive varios días. Así es como la vida de un eosinófilo es mucho más larga que la de un neutrófilo, y puede extenderse por semanas en los tejidos, especialmente en aquellos con una interfase epitelial que la separa del medio, como el tracto respiratorio, gastrointestinal y genitourinario. Tienen un núcleo bilobulado y tienen abundantes gránulos en su citoplasma, ricos en proteínas cat
iónicas que no solo le dan sus propiedades tintoriales al eosinófilo , sino que le sirven para muchas de sus propiedades funcionales. Las cuatro proteínas catiónicas son: la Proteína básica mayor, la Peroxidasa eosinofílica, la Proteína catiónica eosinofílica y la Neurotoxina derivada de los eosinófilos. Otro constituyente de los eosinófilos pero no de sus gránulos es la Lisofosfolipasa, responsable de la formación de los cristales de Charcott Leyden, a menudo encontrados en esputo, heces y tejidos। Además de sus gránulos con contenido preformado los eosinófilos sintetizan mediadores lipídicos , incluyendo 5-lipooxigenasa, Leucotrieno C2 y Factor activador de plaquetas. También son origen de varias citoquinas. Sin embargo, las proteínas catiónicas pueden ser tóxicas para el huésped también, y pueden contribuir a la patogénesis de enfermedades en que el número de eosinófilos es alto.
iónicas que no solo le dan sus propiedades tintoriales al eosinófilo , sino que le sirven para muchas de sus propiedades funcionales. Las cuatro proteínas catiónicas son: la Proteína básica mayor, la Peroxidasa eosinofílica, la Proteína catiónica eosinofílica y la Neurotoxina derivada de los eosinófilos. Otro constituyente de los eosinófilos pero no de sus gránulos es la Lisofosfolipasa, responsable de la formación de los cristales de Charcott Leyden, a menudo encontrados en esputo, heces y tejidos। Además de sus gránulos con contenido preformado los eosinófilos sintetizan mediadores lipídicos , incluyendo 5-lipooxigenasa, Leucotrieno C2 y Factor activador de plaquetas. También son origen de varias citoquinas. Sin embargo, las proteínas catiónicas pueden ser tóxicas para el huésped también, y pueden contribuir a la patogénesis de enfermedades en que el número de eosinófilos es alto.El número de eosinófilos en sangre no siempre refleja el grado de infiltración eosinofílica tisular. Usualmente los eosinófilos están en un número de 450/ ml en sangre periférica. Este conteo tiene una variación diurna siendo mayor en la mañana temprano, y cayendo a medida que los corticosteroides endógenos elevan su nivel. La eosinopenia ocurre con la administración de corticosteroides, y es también frecuente con la infección bacteriana y viral activas. En pacientes con eosinofilias de varias etiologías, los eosinófilos circulantes pueden exhibir cambios morfológicos y funcionales consecuencia de su activación. En algunos, pero no necesariamente en todos los pacientes con eosinofilias sostenida se produce daño tisular especialmente cardíaco como sucede en el síndrome hipereosinofílico. . Evidentemente el daño tisular no es relación solamente de la concentración de eosinófilos sino de la activación de los mismos.
El eosinófilo cumple varias funciones inmunológicas, como los neutrófilos pueden servir como efector final, pero actúan principalmente en la defensa contra parásitos multicelulares que no pueden ser erradicados por fagocitosis. Aunque pueden tener un efecto de fagocitosis y lisis bacteriana y de otros pequeños microbios, estas células no tienen gran capacidad de defensa contra tales patógenos microbianos, y no pueden reemplazar a los neutrófilos en situciones de deficiencia de estos. Es decir que los eosinófilos se constituyen en la principal d
 efensa contra parásitos multicelulares y Helmintos.
efensa contra parásitos multicelulares y Helmintos.En cuanto a la relación de los eosinófilos con las enfermedades alérgicas incluyendo al Asma, ellos elaboran mediadores lipídicos específicos, incluyendo Leucotrieno C4 y Factor activador de las plaquetas, que pueden contraer el músculo liso de la vía aérea, promover la secreción de moco, alterar la permeabilidad vascular, y producir infiltración neutrofílica y eosinofílica .
Se define eosinofilia como la presencia de más de 600 eosinófilos/ml. Mientras que hipereosinofilia se considera cuando hay mas de 1500 eosinófilos /ml.
En las eosinofilias puede haber aumento de eosinófilos además de la sangre, en otros líquidos corporales como líquido cefalorraquídeo, orina, así como en muchos tejidos corporales (piel, vejiga, corazón, pulmón, nervios periféricos y músculo).
Las eosinofilias pueden ser secundarias o primarias.
Las eosinofilias secundarias son un fenómeno reactivo conducido por células no mieloides , que generan IL5, IL3, y Factor estimulante de colonias granulocito-macrofágico(GM-CSF). Los eosinófilos maduros son derivados a la sangre de donde migran rápidamente a los tejidos periféricos de la mucosa bronquial, gastrointestinal y piel. S u sobreviva no es larga a menos que sea bloqueada su apoptosis por la IL5, IL3 y GM-CSF. La producción no regulada de estas citoquinas por varias poblaciones celulares da origen a las eosinofilias secundarias como las vistas por ejemplo en Enfermedad de Hodgkin, carcinoma transicional de vejiga, adenocarcinoma de estómago, colon, útero, reacciones alérgicas, infecciones parasitarias etc.
La eosinofilias primarias incluyen a las clonales como a las idiopáticas(Síndrome hipereosinofílico primario). Ambos se definen por la presencia de eosinofilia de mas de 6 meses, sin evidencia de causas reactivas y con signos y síntomas de compromiso orgánico. Las clonales incluyen a la Leucemia Mieloide Crónica, la Leucemia Mieloide Aguda y algunos Síndromes Mielodisplásicos que cursan con eosinofilia.
Hay algún grado de superposición entre los Síndromes Hipereosinofílicos Primarios(SHP) y las hipereosinofilias por expansión clonal. Por eso la OMS ha intentado buscar criterios de diferenciación entre el SHP y la Leucemia Mieloide Crónica con diferenciación eosinofílica (LCE). Esta última se confirma por evidencias citogenéticas o moleculares de clonalidad, un aumento de blastos de >2% en sangre periférica o >5% de blastos en médula ósea (aunque menos de 19%), y además son excluidas otras causas. El SHP es un diagnóstico de exclusión en pacientes con eosinofilia prolongada
CLÍNICAEs importante obtener una historia clínica completa que incluya viajes realizados a zonas endémicas de ciertas infecciones incluyendo infecciones helmínticas. La Coccidioidomicosis, y la Aspergilosis broncopulmonar alérgica (Asma Aspergilar) son las únicas infección fúngicas asociada frecuentemente a eosinofilia. También averiguar por uso de medicamentos así como la supresión de estos ya que la eosinofilia puede persistir mucho tiempo después de la cesación del uso. Interrogar sobre síntomas de Linfomas especialmente Linfoma de Hodgkin. Una historia sugestiva de insuficiencia suprarrenal, incluyendo la suspensión de
 corticosteroides administrados puede ser orientadora. La enfermedad de Addison es la endocrinopatía que mas frecuentemente produce eosinofilia. Evaluación de síntomas respiratorios, cardiovasculares incluyendo disnea de esfuerzo, fatiga, fiebre, mialgias, rash, cambios visuales y debilidad pueden indicar compromiso orgánico específico
corticosteroides administrados puede ser orientadora. La enfermedad de Addison es la endocrinopatía que mas frecuentemente produce eosinofilia. Evaluación de síntomas respiratorios, cardiovasculares incluyendo disnea de esfuerzo, fatiga, fiebre, mialgias, rash, cambios visuales y debilidad pueden indicar compromiso orgánico específicoEn cuánto al examen físico es muy importante que éste sea exhaustivo, ya que los cuadros que cursan con eosinofilias pueden afectar piel, cerebro, ojos , ganglios, pulmones, corazón, hígado, bazo, intestino, hueso, y nervios periféricos. Las embolias de colesterol debido a ateroesclerosis, con o sin cateterización vascular reciente puede presentarse con eosinofilia y daño orgánico en riñones, piel, miembros inferiores (síndrome de blue/toe)
Causas de Eosinofilia
La nemotecnia CHINA (Conectivopatias, Helmintos, Idiopático SHP, Neoplasias, Alergias), para no dejar de lado ningún grupo de entidades al momento de hacer diagnóstico diferencial
Conectivopatías:
Enfermedad de Churg Strauss
Artritis Reumatoidea
Fascitis eosinofílica
Infecciones Helmínticas
Ascariasis
Esquistosomiasis
Triquinosis
Larva migrans visceral
Gnatostomiasis
Estrongiloidiasis
Fasciolasis
Paragonimiasis
Síndrome Hipereosinofílico Primario
NeoplasiasLinfoma (Hodgkin y no Hodgkin)
Leucemia/Linfoma de celulas T del adulto
Virus Linfotropo de celulas T humanos
Leucemia eosinofílica
Carcinoma gástrico o pulmón ( eosinofilia paraneoplásica)
Mastocitosis
Enfermedades/atópicas alergicas
Asma
Rinitis alérgica
Otras causas
Síndrome mialgia eosinofilia (debido a Triptófano EE UU 1989)
Síndrome del aceite de Colza (España 1981)
Coccidioidomicosis
Angioedema episódico con eosinofilia
Síndrome de Hiper IgE
Síndrome de Omenn
Rechazo de órganos(riñón, pulmón, hígado)
Insuficiencia suprarrenal (Enfermedad de Adisson)
Enfermedad ateroembólica
Irritación de serosas incluyendo diálisis peritoneal
Laboratorio:Realizar siempre hemograma completo con un recuento porcentual y absoluto de eosinófilos.
Estudios dirigidos a determinar compromiso de órganos específicos(hígado, riñón).
A veces está indicada la punción lumbar para investigar eosinofilia en LCR ,cuando se sospecha algunas infecciones helmínticas, reacción por drogas o meningitis por Coccidioides.
En los pacientes con rinitis alérgica se puede realizar un extendido de secreción nasal en busca de eosinófilos, y en los pacientes con Asma se pueden buscar eosinófilos en esputo.
El sedimento urinario puede servir en caso de infección por algunos parásitos o en el caso de sospechar nefritis intersticial alérgica por drogas en cuyo caso la investigación de eosinófilos en orina debe realizarse con técnica de Hansel. Cuando se sospecha Esquistosomiasis , la cistoscopia debe realizarse en búsqueda de huevos
La materia fecal debe analizarse en busca de huevos y parásitos.
Si no se encuentra una causa de eosinofilia secundaria debe hacerse PAMO (punción aspiración de médula ósea), y eventual biopsia de MO, buscando clonalidad. La presencia en sangre periférica de macrocitosis, trombocitosis granulocitopoyesis con desviación a la izquierda así como blastos circulantes debe hacer sospechar clonalidad. En médula ósea, la presencia de dishematopoyesis y fibrosis son sugestivas de clonalidad. La tinción para triptasa así como el inmunofenotipo debe hacerse si se sospecha eosinofilia primaria.
Imágenes
Las imágenes pueden ser de ayuda diagnóstica en algunas situaciones . La TAC toracoabdominopelviana para evaluar compromiso de distintos órganos por eosinofilia. En hígado pueden verse lesiones focales en casos de Fasciola hepática. La Coccidioidomicosis puede dar lesiones pulmonaresque son visibles en Rx y TAC. Los linfomas(Hodgkin y no Hodgkin) pueden mostrar adenomegalias en abdomen.
El ecocardiograma puede mostar trombos murales , compromiso endocárdico en casos de Síndrome Hipereosinofílico primario
Tratamiento
La mayoría de los casos de eosinofilia son tratados de acuerdo a la causa que la originó. Las enfermedades alérgicas y del tejido conectivo pueden ser pasibles del tratamiento con corticosteroides, en cambio las infecciones fúngicas y parasitarias pueden empeorar con los mismos.
En pacientes con eosinofilias primarias , si no hay daño tisular o compromiso de órgano específico el tratamiento no es necesario. En estas situaciones la función cardíaca por ecocardiograma debe ser periódicamente evaluada. La respuesta a los corticosteroides debe ser evaluada tanto para pronóstico(los respondedores a los corticoides tienen me

jor pronóstico), como para elegir opciones cuando el tratamiento esté indicado.
El tratamiento de las eosinofilias primarias con compromiso orgánico incluye corticosteroides Alfa INF en casos de resistencia a los mismos. Otros agentes se usan en casos de resistencia a esteroides com Hydroxiurea, Clorambucil, Vincristina, Citarabina y Etopósido. En los casos de mutaciones específicas puede usarse Imatinib que ha logrado remisiones duraderas. En casos de resistencia a múltiples regímenes la combinación de agentes quimioterápicos, inhibidores de la Tirosin Kinasa y anticuerpos monoclonales están siendo estudiados. Recientemente Mepolizumab, un anticuerpo monoclonal humanizado anti IL5, se mostró efectivo en pacientes con Síndrome Hipereosinofílico primario sin mutaciones que hicieran sospechar clonalidad y que tenían requerimientos altos de corticoides para controlar la enfermedad.
Pronóstico
Depende de la condición asociada a la eosinofilia. Muchas enfermedades helmínticas se cronifican causando morbilidad pero no mortalidad lo mismo que muchas enfermedades alérgicas.
El pronóstico de la eosinofilias primarias es determinado por el grado de compromiso orgánico, el diagnóstico precoz , la respuesta al tratamiento y las alteraciones citogenéticas así como la patofisiología molecular
No hay comentarios:
Publicar un comentario